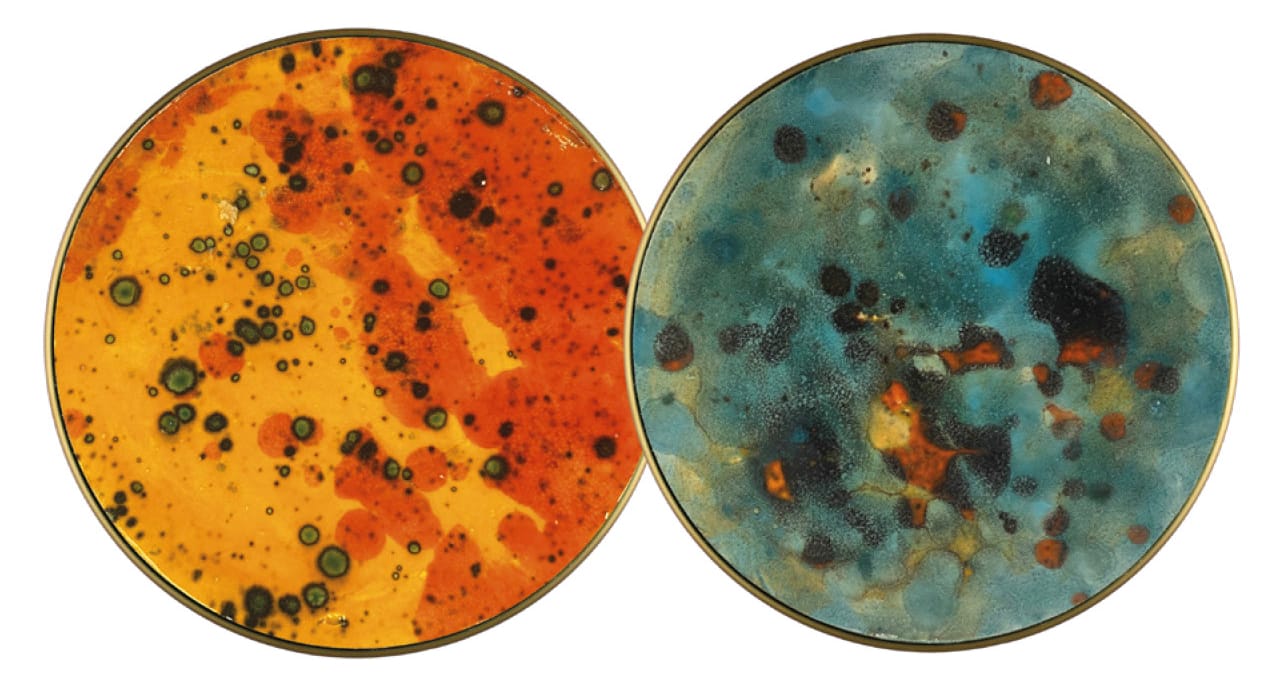

Opis
CHAMALEON ACB to złota lub czarna podstawa ze zintegrowanym źródłem światła i wymiennymi dyskami z różnymi zdobieniami- od metalowych, przez naturalny kamień, ceramikę, mech czy panele akustyczne.
Dyski z mchem chrobotkiem wykonane są w 100% z naturalnego, konserwowanego mchu. Każdy krążek jest wykonywany ręcznie, dlatego poszczególne egzemplarze mogą się nieznacznie różnić. Dekoracje z mchu poprawiają akustykę, pomagają kontrolować wilgotność w pomieszczeniu, redukują hałas, są niepalne, niealergizujące i nie emitują CO2. Nie wymagają pielęgnacji ani wody. Mech może wydzielać drzewny zapach, który znika po 3-4 tygodniach i jest nieszkodliwy dla zdrowia. Do użytku wewnątrz pomieszczeń.
Panel akustyczny to produkt ekologiczny, wykonany w 60% z przetworzonych butelek PET i w 40% z nowego PET. Znacznie poprawia akustykę (w połączeniu z innymi wariantami paneli akustycznych).
Ceramika wykonana jest lokalnie (Manises) w Walencji, w całości ręcznie i na wymiar. Można je łączyć z własnymi dekoracjami,zastawą stołową lub tradycyjnymi i/lub ręcznie robionymi przedmiotami. Ponieważ są to produkty rękodzielnicze, mogą wystąpić różnice w kolorze, fakturze i grubości.
Możliwości jeszcze większej personalizacji- w tym celu skontaktuj się z nami.
- Istnieje możliwość wykonania dysków w innych kolorach chrobotka ( naturalny biały, ciemny różowy, fioletowy, zielony, ciemny niebieski, czarny) -minimum zamówienia wynosi 25 sztuk
 Dyski metalowe w innych kolorach RAL-minimum zamówienia wynosi 10 sztuk
Dyski metalowe w innych kolorach RAL-minimum zamówienia wynosi 10 sztuk- Panele akustyczne mogą być wykonane również w poniższych kolorach-minimum zamówienia wynosi 25 sztuk

- Ceramika w innych kolorach – minimum zamówienia wynosi 25 sztuk

Dyski metalowe w innych kolorach RAL-minimum zamówienia wynosi 10 sztuk
Dyski metalowe w innych kolorach RAL-minimum zamówienia wynosi 10 sztuk











Opinie
Na razie nie ma opinii o produkcie.